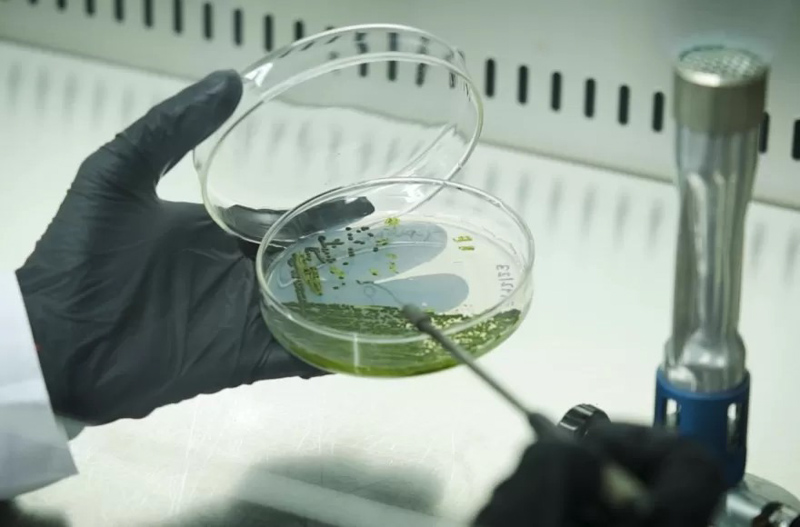

Talleractual.com proporciona a los usuarios los recursos técnicos adecuados para que, con carácter previo a brindar Información Personal, puedan acceder a esta Política de Privacidad y puedan dar su consentimiento a fin de que Talleractual.com proceda al tratamiento automatizado de sus datos personales.
En cuanto a los formularios electrónicos de recolección de datos del sitio web, salvo en los campos en que se indique lo contrario, las respuestas a las preguntas sobre datos personales son voluntarias, sin que la falta de contestación implique una disminución en la calidad o cantidad de los servicios correspondientes, a menos que se indique expresamente lo contrario. Cuando usted nos suministre voluntariamente datos de carácter personal, nos está autorizando para utilizar dicha Información Personal de acuerdo con los términos y condiciones de nuestra Política de Privacidad.
El usuario garantiza que los datos personales facilitados a Talleractual.com son veraces y se hace responsable de comunicar a ésta cualquier modificación en los mismos. Talleractual.com puede guardar y procesar su Información Personal u otros datos personales para entender mejor sus necesidades y el modo en el que podemos mejorar nuestros productos y servicios. Asimismo, podemos utilizar su Información Personal para contactarlo, (por ejemplo, para personalizar la información de los productos o servicios que le ofrezcamos, para poder enviarle materiales de marketing o promoción o para poder responder a sus comentarios o solicitudes de información). Cualquier cambio en esta Política de Privacidad será publicado en la sección de Términos de uso de este sitio web. Esto le permitirá conocer a Usted conocer en cualquier momento qué información estamos guardando y cómo recolectamos y usamos dicha información. Usted deberá tener en cuenta que entregaremos su Información Personal a autoridades competentes si es requerida por las mismas.
4. Seguridad
Talleractual.com se compromete a tratar su Información Personal con la máxima privacidad, confidencialidad y seguridad y a proteger sus datos personales mediante todos los medios técnicos a su alcance para evitar la pérdida, mal uso, acceso no autorizado, alteración y destrucción. En algunos casos, será necesario que transmitamos sus consultas a otras compañías específicas del Grupo Talleractual.com. También en estos casos su Información Personal serán tratados de manera confidencial.
5. Menores
Talleractual.com pide a los padres o tutores que informen a los menores de edad acerca del uso responsable y seguro de sus datos de carácter personal cuando utilicen internet o participen en actividades online. Talleractual.com no tiene intención de recoger Información Personal de menores de 18 años. Cuando sea preciso, Talleractual.com dará instrucciones específicas a los menores para que no proporcionen datos de carácter personal en nuestros anuncios o sitios web. Si un menor nos proporciona datos de carácter personal, el padre o tutor del menor deberá ponerse en contacto con nosotros en caso de que desee que cancelemos dicha información de nuestros registros. En tal supuesto, cancelaremos la información del menor de nuestras bases de datos.
6. Información no personal recogida automáticamente
Nuestro servicio web recoge automáticamente determinada información no personal sobre el uso de nuestro sitio web que se almacena en nuestros servidores para fines exclusivamente internos, como pueden ser facilitar su visita a nuestro sitio web, mejorar su experiencia online o para finalidades estadísticas de acceso. Ejemplos de este tipo de información no personal incluyen el nombre de su proveedor de servicios de Internet, el tipo de navegador de Internet o el sistema operativo utilizado por usted y el nombre de dominio del sitio web desde el cual ha llegado a nuestro sitio o anuncio. En tal sentido, cuando usted visita nuestro sitio web, en algunos casos podemos recoger información sobre usted que no sea Información Personal (Ej: su tipo de navegador de Internet o su sistema operativo, el nombre de dominio del sitio web usado, etc.), y la misma podría ser almacenada en su ordenador en forma de "cookie" o similar que nos ayudará en diversas formas, como por ejemplo, permitirnos adecuar nuestro sitio web o anuncio a sus intereses y preferencias. En la mayoría de los navegadores de Internet usted puede eliminar las "cookies" del disco duro de su ordenador, bloquear todas las "cookies" o recibir un aviso antes de que se instale una "cookie". Por favor, consulte las instrucciones de su navegador o la pantalla de ayuda para saber más sobre el funcionamiento de estas funciones.
7. Cookies (ver apartado)
8. El uso de complementos de redes sociales
Los complementos (“plug-ins”) de las redes sociales Facebook Instagram y Twitter pueden ser incorporados en nuestras páginas web. Los servicios asociados provienen respectivamente de las compañías Facebook Inc. y Twitter Inc. (o “proveedores”).
La red social de Facebook es operada por Facebook Inc., 1601 S. California Ave, Palo Alto, CA 94304, USA ("Facebook"). Para conocer más detalles de los complementos de Facebook y su apariencia visite: https://developers.facebook.com/docs/plugins.
La red social de Facebook es operada por Facebook Inc., 1601 S. California Ave, Palo Alto, CA 94304, USA ("Facebook"). Para conocer más detalles de los complementos de Facebook y su apariencia visite: https://developers.facebook.com/docs/plugins.
El Servicio de Instagram es uno de los Productos de Facebook que Facebook, Inc. te proporciona. Para conocer más detalles de los complementos de Instagram y su apariencia visite: https://about.instagram.com/community/safety
Twitter es operado por Twitter Inc, 1355 Market St, Suite 900, San Francisco, CA 94103, USA. Para conocer más detalles de los complementos de Twitter y su apariencia visite: https://dev.twitter.com/web/tweet-button
Para mejorar la protección de sus datos, cuando visite nuestras páginas web estos complementos se implementan como botones sociales. Esta forma de integración asegura que, al acceder a una de las páginas que contienen estos complementos, el usuario no se conecta de forma automática a los servidores de los proveedores. Sólo con la activación de los complementos el navegador creará un enlace directo a los servidores de los proveedores. El contenido de varios complementos se transmite entonces desde el respectivo proveedor directamente al navegador del usuario y posteriormente aparecerá en la pantalla.
Los complementos informan al proveedor de las páginas que ha visitado el usuario. Cuando se navega por nuestra web conectado con el nombre de usuario de Facebook, Instagram o Twitter, el proveedor puede visualizar los intereses del usuario, es decir la información que está visitando. Haciendo uso de estas opciones (por ejemplo, hacer un “me gusta” o escribir un comentario), esta información también se transmitirá a su cuenta de usuario de Facebook, Instagram y Twitter.
Información adicional sobre la recogida y uso de estos datos que haga Facebook, Instagram y Twitter así como los derechos y posibilidades disponibles para proteger su privacidad en este contexto se puede encontrar en la información de protección de datos de Facebook, Instagram y Twitter:
Protección de datos/ privacidad de Facebook: http://www.facebook.com/policy.php
Protección de datos/ privacidad de Instagram: https://about.instagram.com/community/safety
Protección de datos/ privacidad de Twitter: http://twitter.com/privacy
Para evitar que Facebook, Instagram y Twitter pueda relacionar la visita a nuestras páginas con su cuenta de usuario debe desconectar su cuenta de usuario antes de visitar nuestras webs.
COOKIES
Este sitio web incorpora cookies de origen y de terceros con el objetivo de mejorar los servicios que le ofrecemos. Puede permitir o no el uso de cookies en el sitio, siempre habiendo la posibilidad de configurar el navegador para ser avisado de la recepción de cookies e impedir su instalación en el equipo. No obstante, la desactivación de las cookies puede afectar al correcto funcionamiento de determinadas secciones del sitio web.
Utilizamos cookies para que pueda sacar más provecho de nuestro sitio web. Las cookies son pequeñas unidades de información que se almacenan de forma temporaria en tu computador o dispositivo móvil para mejorar su experiencia al navegar el sitio web. Las cookies incluyen a menudo un único identificador: un número anónimo que se genera aleatoriamente y se almacena en su dispositivo. Algunas son temporales y expiran cuando el usuario finaliza la navegación en la página web mientras que otras permanecen por un tiempo en el dispositivo.
Tipos de cookies
Este sitio web incorpora dos tipos de cookies:
Cookies de Origen
Las cookies de origen son establecidas por el sitio web que visite y únicamente pueden ser leídas por el sitio en particular.
Cookies de terceros
Las cookies de terceros son establecidas por otras organizaciones que prestan sus servicios a nuestro sitio web. Por ejemplo, servicios analíticos externos establecen determinadas cookies en nuestro sitio para poder analizar qué es tendencia y qué no. Cuando visite una página web, puede por ejemplo tener contenido de YouTube y este podrá establecer su propia política de cookies.
¿Por qué debo permitir el uso de cookies?
Las cookies contienen información que permite mejorar los servicios que le ofrecemos. Por ejemplo:
- Permiten al sitio reconocer su dispositivo así que no es necesario repetir la misma información durante una tarea o sesión. Por ejemplo, rellenar un formulario o una encuesta web
- Dan apoyo a la función de Mi Colección
- Permiten que el reproductor de vídeo funcione correctamente
- Cifran la cantidad de personas que utilizan los servicios, permitiendo que se puedan utilizar más fácilmente y asegurando que tengan la suficiente capacidad de hacerlos funcionar rápidamente. Analizan datos anónimos para ayudarnos a entender cómo la gente interactúa con los diferentes aspectos de nuestros servicios on-line y así mejorarlos
¿Qué ocurre si no consiento el uso de cookies?
Si usted decide no aceptar el uso de cookies, algunas secciones de este sitio web quedarán deshabilitadas o no le funcionaran correctamente. Esto puede restringirle las funciones de la página y puede tener un impacto en el diseño o en la experiencia de su visita.
Ejemplos de funciones que pueden quedar afectadas:
- Hacer uso de la función Mi Colección
- Recibir una experiencia personalizada de nuestro sitio web
- Reproducir vídeos
- Compartir la página en redes sociales
- Visualizar contenido de terceros
Tipos de cookies que se utilizan en este sitio web
Además de las cookies antes mencionadas, otras cookies de origen o de terceros podrían ser utilizadas en contenido (externo) añadido en este sitio web, utilizando tecnologías como iFrames, JavaScript, etc. Al aceptar cookies, también aceptas que dicho contenido puede utilizar cookies.
Talleractual.com no tiene control ni acepta la responsabilidad por las cookies de terceros. Por favor revisa el sitio web del tercero para obtener más información.